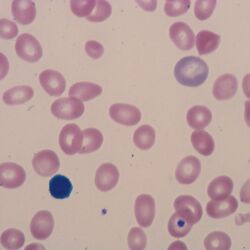

Anisocytosis
From haematologyetc.co.uk
Derivation: From the Greek Aniso [Unequal] and Greek Cytosis [referring to a cell]
Description
Like poikilocytosis, this simple term simply describes variation between cells – in this case their size when flattened on blood smears; the term is often used as a “catch all” description, but lacks value since it does not describe how cells vary (e.g. large and normal, small and normal etc) or the type of cells involved.
Appearance: The key points are that different cells have variability in size, often such cells will also have variability in shape (poikilocytosis). A small image from a clinical case is shown for comparison.
Significance
Although a non-specific term there is a value in recognising anisocytosis: on a normal smear red cells present a fairly uniform population. In disease states, one of the first changes noticed by the morphologist is an increased variation either in cell shape or cell size. Anisocytosis should not be regarded as a diagnosis, and the term generally has little value to clinicians. However, for a morphologist spotting this variation should be an indication to look further.
Pitfalls
Always make sure there is not a better term to use than anisocytosis – why is there variability in size? Could the appearances better be described by another term?
Recommendation
Look for anisocytosis but avoid using it as a description term on a report – it is always better to describe the nature of the variation (see images).
Gallery
Clinical Image 1: Variation in size is very obvious, but why? Here the key point is that the smaller cells are in fact irregularly contracted cells and are much better desribed as such. Clinical condition: Haemoglobin C disease
Clinical Image 2: More vaiability in size, in this case caused by enlarged and slightly ovoid cells - oval macrocytes. Clinical condition: B12 deficiency.